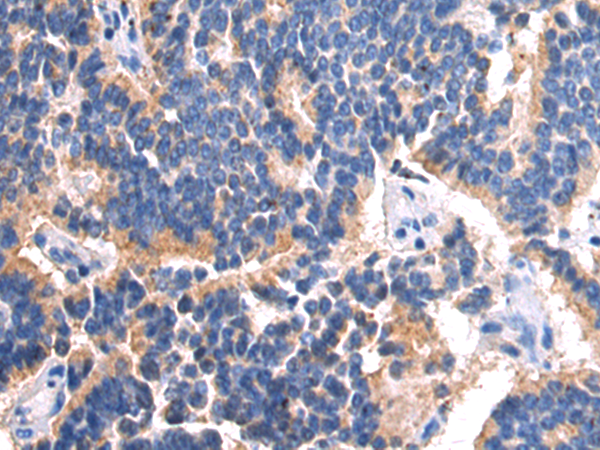
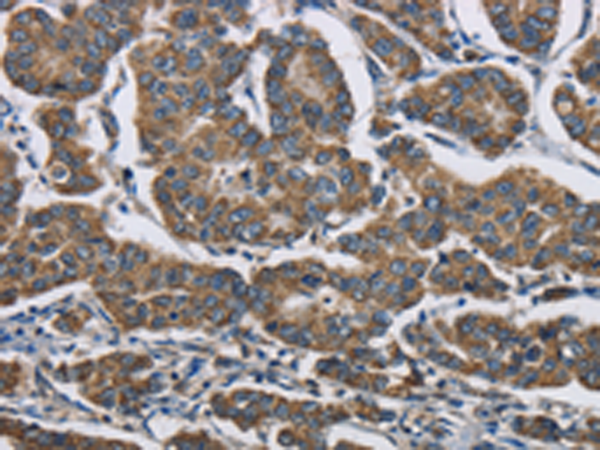
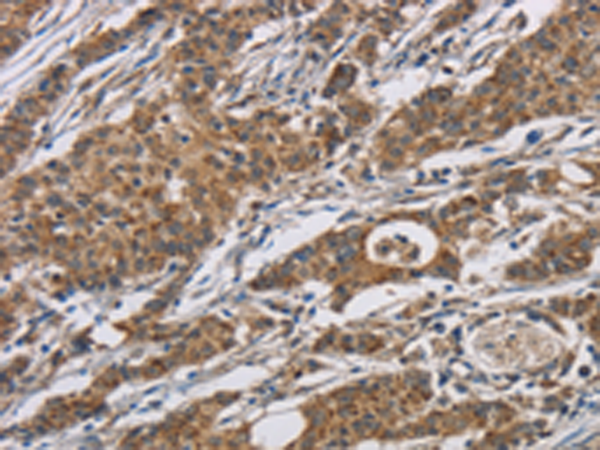

-
分类: 科研抗体货号: P06946别名: EL52; HSPN; LAP2; HSP86; HSPC1; HSPCA; Hsp89; Hsp90; LAP-2; HSP89A; HSP90A; HSP90N; HSPCAL1; HSPCAL4应用: WB反应种属: Human, Mouse, Rat
-
分类: 科研抗体货号: P06909别名: ARTD2; ADPRT2; PARP-2; ADPRTL2; ADPRTL3; pADPRT-2应用: WB反应种属: Human, Mouse
-
分类: 科研抗体货号: P06944别名: FN; CIG; FNZ; MSF; ED-B; FINC; GFND; LETS; GFND2应用: IHC反应种属: Human, Mouse, Rat
-
分类: 科研抗体货号: P06906别名: NADP-ME应用: WB,IHC反应种属: Human, Mouse
-
分类: 科研抗体货号: P06940别名: CMS10; CMS1B; FADS3; C4orf25应用: WB反应种属: Human, Mouse
-
分类: 科研抗体货号: P06959别名: VASA应用: WB,IHC反应种属: Human, Mouse
-
分类: 科研抗体货号: P06938别名: CPSD; CLN10; HEL-S-130P应用: WB,IHC反应种属: Human, Mouse, Rat
-
分类: 科研抗体货号: P06958别名: BGR, BRGL, PRTDNY3, PRTD-NY3应用: IHC反应种属: Human
-
分类: 科研抗体货号: P06937别名: Ga55应用: IHC反应种属: Human, Mouse
-
分类: 科研抗体货号: P06957别名: RAGE应用: WB,IHC反应种属: Human

鄂公网安备42018502007531号
鄂公网安备42018502007531号

